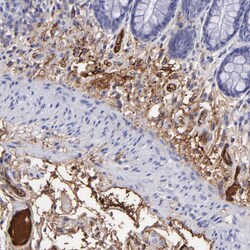
Invitrogen FIBB Polyclonal Antibody 100 &mu;L | Buy Online | Invitrogen&trade; | Fisher Scientific

missing translation for 'onlineSavingsMsg'
Läs mer
Läs mer
Invitrogen™ FIBB Polyclonal Antibody


Beskrivning
Immunogen sequence: ERKAPDAGGC LHADPDLGVL CPTGCQLQEA LLQQERPIRN SVDELNNNVE AVSQTSSSSF QYMYLLKDLW QKRQKQVKDN ENVVNEYSSE LEKHQLYIDE TVNSNIPTNL RVLRSILENL RSKIQKLE Highest antigen sequence indentity to the following orthologs: Mouse - 74%, Rat - 73%.
FIBB is the beta component of fibrinogen, a blood-borne glycoprotein comprised of three pairs of nonidentical polypeptide chains. Following vascular injury, fibrinogen is cleaved by thrombin to form fibrin which is the most abundant component of blood clots. In addition, various cleavage products of fibrinogen and fibrin regulate cell adhesion and spreading, display vasoconstrictor and chemotactic activities, and are mitogens for several cell types. Mutations in its gene lead to several disorders, including afibrinogenemia, dysfibrinogenemia, hypodysfibrinogenemia and thrombotic tendency.

Specifikationer
Specifikationer
| Antigen | FIBB |
| Användningsområden | Immunohistochemistry (Paraffin), Western Blot, Immunocytochemistry |
| Klassificering | Polyclonal |
| Koncentration | 0.4 mg/mL |
| Konjugera | Unconjugated |
| Formulering | PBS with 40% glycerol and 0.02% sodium azide; pH 7.2 |
| Gen | Fgb |
| Genaccessionsnr. | P02675 |
| Gene Alias | 2510049G14Rik; Ab1-181; Ab1-216; Ac1-581; B beta polypeptide; beta-fibrinogen; epididymis secretory sperm binding protein Li 78p; Fgb; fibrinogen; Fibrinogen beta chain; fibrinogen, B beta polypeptide; fibrinogen, beta polypeptide; Fibrinopeptide B; HEL-S-78p; Liver regeneration-related protein LRRG036/LRRG043/LRRG189; MGC104327; MGC120405 |
| Gensymboler | Fgb |
| Visa mer |
Produkttitel
Genom att klicka på Skicka bekräftar du att du kan bli kontaktad av Fisher Scientific angående feedbacken du har lämnat i detta formulär. Vi kommer inte att dela din information för andra ändamål. All kontaktinformation som tillhandahålls ska också underhållas i enlighet med vår Sekretesspolicy.
Hittar du en möjlighet till förbättring?